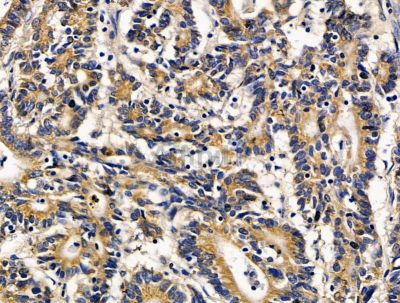
SPPL2B Antibody - DF15613 at 1/100 staining human colorectal cancer by IHC-P.

SPPL2B Antibody - #DF15613
Related Downloads
Protocols
Product Info
*The optimal dilutions should be determined by the end user. For optimal experimental results, antibody reuse is not recommended.
*Tips:
WB: For western blot detection of denatured protein samples. IHC: For immunohistochemical detection of paraffin sections (IHC-p) or frozen sections (IHC-f) of tissue samples. IF/ICC: For immunofluorescence detection of cell samples. ELISA(peptide): For ELISA detection of antigenic peptide.
Fold/Unfold
IMP4; Intramembrane protease 4; Protein SPP-like 2B; SPPL2B;
Immunogens
A synthesized peptide derived from human SPPL2B.
- Q8TCT7 SPP2B_HUMAN:
- Protein BLAST With
- NCBI/
- ExPASy/
- Uniprot
MAAAVAAALARLLAAFLLLAAQVACEYGMVHVVSQAGGPEGKDYCILYNPQWAHLPHDLSKASFLQLRNWTASLLCSAADLPARGFSNQIPLVARGNCTFYEKVRLAQGSGARGLLIVSRERLVPPGGNKTQYDEIGIPVALLSYKDMLDIFTRFGRTVRAALYAPKEPVLDYNMVIIFIMAVGTVAIGGYWAGSRDVKKRYMKHKRDDGPEKQEDEAVDVTPVMTCVFVVMCCSMLVLLYYFYDLLVYVVIGIFCLASATGLYSCLAPCVRRLPFGKCRIPNNSLPYFHKRPQARMLLLALFCVAVSVVWGVFRNEDQWAWVLQDALGIAFCLYMLKTIRLPTFKACTLLLLVLFLYDIFFVFITPFLTKSGSSIMVEVATGPSDSATREKLPMVLKVPRLNSSPLALCDRPFSLLGFGDILVPGLLVAYCHRFDIQVQSSRVYFVACTIAYGVGLLVTFVALALMQRGQPALLYLVPCTLVTSCAVALWRRELGVFWTGSGFAKVLPPSPWAPAPADGPQPPKDSATPLSPQPPSEEPATSPWPAEQSPKSRTSEEMGAGAPMREPGSPAESEGRDQAQPSPVTQPGASA
Research Backgrounds
Intramembrane-cleaving aspartic protease (I-CLiP) that cleaves type II membrane signal peptides in the hydrophobic plane of the membrane. Functions in ITM2B and TNF processing. Catalyzes the intramembrane cleavage of the anchored fragment of shed TNF-alpha (TNF), which promotes the release of the intracellular domain (ICD) for signaling to the nucleus. May play a role in the regulation of innate and adaptive immunity. Catalyzes the intramembrane cleavage of the simian foamy virus processed leader peptide gp18 of the envelope glycoprotein gp130 dependently of prior ectodomain shedding by furin or furin-like proprotein convertase (PC)-mediated cleavage proteolysis.
Glycosylated.
Cell membrane>Multi-pass membrane protein. Golgi apparatus membrane>Multi-pass membrane protein. Lysosome membrane>Multi-pass membrane protein. Endosome membrane>Multi-pass membrane protein. Membrane>Multi-pass membrane protein>Lumenal side.
Note: targeted through the entire secretory pathway to endosomes/lysosomes (PubMed:15998642).
Expressed predominantly in adrenal cortex and mammary gland.
The PAL motif is required for normal active site conformation. The catalytic domains embedded in the membrane are in the opposite orientation to that of the presenilin protein family; therefore, it is predicted to cleave type II-oriented substrate peptides like the prototypic protease SPP.
Belongs to the peptidase A22B family.
Restrictive clause
Affinity Biosciences tests all products strictly. Citations are provided as a resource for additional applications that have not been validated by Affinity Biosciences. Please choose the appropriate format for each application and consult Materials and Methods sections for additional details about the use of any product in these publications.
For Research Use Only.
Not for use in diagnostic or therapeutic procedures. Not for resale. Not for distribution without written consent. Affinity Biosciences will not be held responsible for patent infringement or other violations that may occur with the use of our products. Affinity Biosciences, Affinity Biosciences Logo and all other trademarks are the property of Affinity Biosciences LTD.